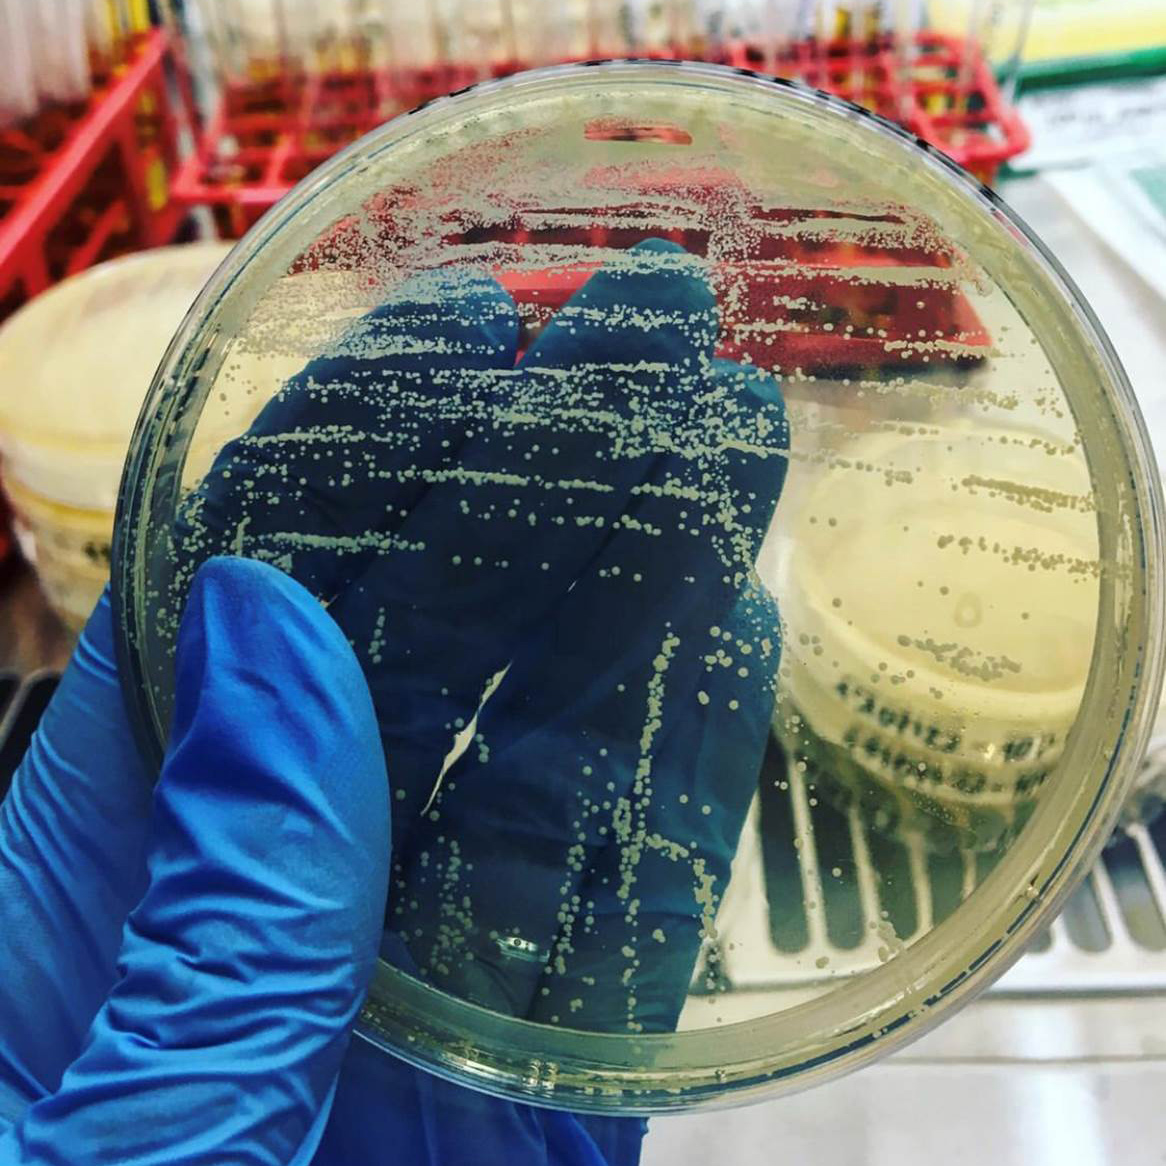

Probiotyki z mleka ludzkiego
Mleko kobiece – niezwykły płyn biologiczny:
- skład mleka jest idealnie dostosowany do potrzeb dziecka na każdym etapie rozwoju - składniki odżywcze oraz bioaktywne;
- skład komórkowy ludzkiego mleka jest dynamiczny, a proporcje różnych typów komórek mogą być zmieniane przez wiele czynników, takich jak np. etap laktacji
- mleko kobiece jest również stałym źródłem komensalnych i pożytecznych bakterii (bakterii kwasu mlekowego i bifidobakterii). Najczęściej występujące bakterie w ludzkim mleku to bakterie z rodzin: Staphylococcus, Acinetobacter, Streptococcus, Pseudomonas, Lactococcus, Enterococcus i Lactobacillus
- białka mleka ludzkiego zaangażowane są w procesy immunologiczne - inhibitory układu dopełniacza (lizozym, laktoferyna, a-laktoalbumina)
Przeprowadzone badania w ramach dwóch projektów:
- 200 próbek mleka kobiecego - izolacja komórek macierzystych
- 1050 hodowli komórek stacjonarnie,
- 100 hodowli komórek w bioreaktorach,
- 22 500 analiz cytometrycznych na obecność 6 specyficznych dla komórek macierzystych genów: CD44, CD29, CD200, CD166, CD146 i CD271,
- 22 500 reakcji PCR 6 genów NANOG, OCT4, LIN28, REX1, SOX2, TERT,
- 450 liofilizacji,
- 1200 analiz liczebności komórek licznikiem automatycznym,
- 880 posiewów mikrobiologicznych.
- 100 próbek mleka kobiecego - izolacja 2000 szczepów bakteryjnych,
- 600 analiz molekularnych
- analiza profilu metabolicznego wraz z zymogramem 6000 rekcji,
- testy hemolizy - 2000 testów,
- testy metabolizmu prebiotyków - 2000 analiz,
- testy adhezji - 2000 testów,
- testy kinetyki wzrostu - 2000 testów,
- antybiotykooporność - 2000 szczepów x 6 antybiotyków = 12 000 analiz,
- odporność na niskie pH oraz sole żółci - 12 000 analiz,
- ekspresja probiogenomu - 4000 analiz,
- sekwencjonowanie genu 16S rRNA przy użyciu metody Sangera - 2000 analiz
- sekwencjonowanie całego genomu do postaci draft i finalnej: sekwencjonowanie nowej generacji (NGS) na platformie Illumina - 2000 reakcji
- hodowle w bioreaktorze i liofilizacja - 150 procesów,